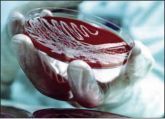

1/2013 (45) январь-март
- Квартальные события
- Новые изменения европейских правил GMP

17 января 2013 Комиссия ЕС опубликовала предложения о внесении изменений в руководящие указания ЕС по надлежащей производственной практике (GМР).
- Начался процесс пересмотра стандарта ISO 14698

На состоявшемся в конце 2012 года заседании представителей национальных органов по стандартизации, посвященном стандартам по чистым помещениям, было принято решение продолжить работу по пересмотру международного стандарта ISO 14698 «Чистые помещения и связанные с ними контролируемые среды.
- Современный взгляд на валидацию очистки

Ассоциация парентеральных препаратов (PDA, Parenteral Drug Association) периодически публикует так называемые технические отчеты, посвященные отдельным аспектам, связанным с промышленной чистотой.
- Осознание GEP:Oтчет о второй конференции «GEP-RUSSIA-2013: Надлежащая инженерная практика»

14-15 февраля 2013 года в Москве уже во второй раз наш журнал провел конференцию «GEP-RUSSIA» для своих постоянных читателей и специалистов, вовлеченных в проектирование и эксплуатацию чистых помещений и связанных с ними технологических сред.
- Организация системы инженерного менеджмента в соответствии с GEP

По материалам второй конференции «GEP-RUSSIA-2013: Надлежащая инженерная практика»
- Чистые помещения
- Основные принципы проектирования и эксплуатации экспериментальнобиологических клиник (Вивариев)

Материал для публикации подготовлен компанией ООО «УНИКА инжиниринг»
- Чистый барьер
- Контроль биозагрязнений
Семинар, организованный компанией Isotron был адресован целому ряду пользователей чистых помещений, от производителей изделий медицинского назначения, до производителей комплектующих изделий и компаний, занимающихся упаковкой по контракту.
- Контроль загрязнений «под башмаком»

This article was published in the July/August 2012 issue of Controlled Environments magazine, pp. 10-13
- Проблемы выбора биоцидов

В предлагаемой Вашему вниманию статье доктор Кэтрин Стейнхауэр рассматривает применение европейских норм по испытанию дезинфектантов в рамках рекомендаций Федерального Управления по контролю качества пищевых продуктов и лекарственных средств США (FDA) для фармацевтической промышленности
- Не забывайте про одежду

Чтобы эффективно исполнять свою роль в контроле загрязнений окружающей среды, технологическая одежда для чистых помещений должна удовлетворять нескольким критериям. Ульрик Костер и Стив Марнач из компании DuPont Personal Protection рассматривают комбинацию требований к одежде по защите персонала и продукции
- Результативная (эффективная) протирка

Влажные салфетки являются эффективным средством очистки для чистых помещений, однако, при неправильном их использовании время, потраченное на тестирование и валидацию таких салфеток, окажется потраченным впустую. Карен Россингтон рассматривает научные основы, скрывающиеся за процессом эффективной протирки.
- Инженерная практика
- Валидация системы получения и распределения сжатого воздуха

Статья посвящена аттестации систем сжатого воздуха в фармацевтической промышленности. Изложенные здесь методология и описанные приспособления могут быть использованы и в других отраслях промышленности (пищевой, электронной, оптической и пр.), а также для других технологических сред (азот, углекислый газ, аргон и др.).
- Концепция проведения валидации систем водоподготовки. Часть 2. Управление рисками

При разработке концепции валидации, основанной на оценке рисков, мы исходили из простой идеи -создать на основе современных принципов GMP простой, понятный и удобный механизм управления рисками.
- Использование неофициальных инструментов оценки рисков в процессе управления изменениями

Практический подход к управлению рисками Келли Уолдрона и Марисса Грэй Статья из журнала Pharmaceutical Technology (октябрь 2012 года), печатается по разрешению Advanstar Communications Inc.
- Современные инженерные решения повышения продуктивности биореакторов

По материалам второй конференции «GEP-RUSSIA-2013: Надлежащая инженерная практика»













